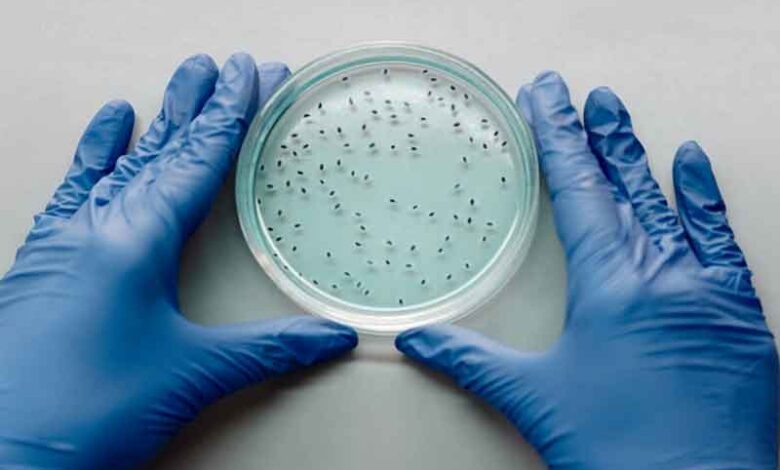

یک منبع پنهان انرژی در بدن انسان کشف شد!
سلولهای ما ممکن است به معنای واقعی کلمه با الکتریسیته کار کنند و به عنوان یک منبع تغذیه پنهان برایشان عمل کند که میتواند به انتقال مواد کمک کند یا حتی در ارتباطات بدن ما نقش داشته باشد.
محققان دانشگاه هوستون(Houston) و دانشگاه راتگرز(Rutgers) در ایالات متحده میگویند موجهای کوچک در غشاهای چربی اطراف سلولهای ما میتوانند ولتاژ کافی را برای استفاده به عنوان منبع مستقیم انرژی برای برخی از فرآیندهای بیولوژیکی تولید کنند.
خود این نوسانات قبلاً به طور گسترده مورد مطالعه قرار گرفتهاند و مشخص شده است که توسط فعالیت پروتئینهای تعبیه شده و تجزیه «آدنوزین تری فسفات»(ATP) که وسیله اصلی انتقال انرژی از طریق سلولهاست، هدایت میشوند.
این مطالعه جدید، پشتیبانی نظری از این احتمال را ارائه میدهد که لرزشهای غشاء به اندازه کافی قوی و ساختار یافته هستند تا بار الکتریکی ایجاد کنند که سلولها میتوانند برای برخی از وظایف مهم از آن استفاده کنند.
محققان در مقاله خود مینویسند: سلولها سیستمهای غیرفعال نیستند، آنها توسط فرآیندهای فعال داخلی مانند فعالیت پروتئین و مصرف ATP هدایت میشوند. ما نشان میدهیم که این نوسانات فعال، هنگامی که با خاصیت الکترومکانیکی جهانی فلکسوالکتریسیته(flexoelectricity) همراه میشوند، میتوانند ولتاژهای غشایی ایجاد کنند و حتی انتقال یون را هدایت کنند.
کلید درک این مدل جدید، مفهوم فلکسوالکتریسیته است. غشاها به طور مداوم در نتیجه نوسان تصادفی گرما در سلول خم میشوند. در تئوری، هر ولتاژی که از این طریق تولید شود، باید در محیطهای تحت تعادل خنثی شود و آنها را به عنوان منبع انرژی بیفایده کند.
محققان استدلال کردند که سلولها در تعادل کامل نیستند و فعالیت درون سلول برای زنده نگه داشتن ما در حال چرخش است. اینکه آیا این برای تبدیل یک غشای لیپیدی به یک موتور کافی است یا خیر، نیاز به چند فرمولبندی دقیق دارد.
طبق محاسبات انجام شده توسط محققان، فلکسوالکتریسیته میتواند اختلاف الکتریکی تا ۹۰ میلیولت بین داخل و خارج سلول ایجاد کند که برای فعال شدن یک نورون کافی است.
ولتاژ تولید شده میتواند به حرکت یونها، اتمهای بارداری که توسط جریان الکتریسیته و مواد شیمیایی کنترل میشوند، کمک کند.
نوسانات غشایی ممکن است برای تأثیرگذاری بر عملیات بیولوژیکی مانند حرکت عضلات و سیگنالهای حسی کافی باشد. این تیم تخمین زد که بارها در مقیاس میلیثانیه ظاهر میشوند و با زمانبندی سیگنالهایی که از طریق سلولهای عصبی موج میزنند، مطابقت دارند.
محققان میگویند که نتایج ما نشان میدهد که فعالیت میتواند ولتاژ و قطبش غشایی را به طور قابل توجهی تقویت کند که نشاندهنده یک مکانیسم فیزیکی برای برداشت انرژی و انتقال هدایتشده یون در سلولهای زنده است.
این یافتهها میتواند در گروههای سلولی نیز گسترش یابد و به توضیح چگونگی هماهنگی غشاهای سلولی برای ایجاد اثرات و بافتهای در مقیاس بزرگتر کمک کند. اکنون مطالعات آینده میتوانند آزمایش کنند که آیا همه اینها مطابق انتظار در داخل بدن کار میکنند یا خیر.
این یافتهها میتوانند پیامدهایی فراتر از بافتهای زنده داشته باشند. محققان ایده استفاده از همین تکنیکهای تولید برق را برای اطلاعرسانی در طراحی شبکههای هوش مصنوعی و مواد مصنوعی مبتنی بر طبیعت مطرح میکنند.
محققان میگویند: بررسی دینامیک الکترومکانیکی در شبکههای نورونی میتواند پلی بین فلکسوالکتریسیته مولکولی و پردازش اطلاعات پیچیده ایجاد کند که پیامدهایی هم برای درک عملکرد مغز و هم برای کشف مواد محاسباتی الهام گرفته از زیستشناسی دارد.
خبر آنلاین




